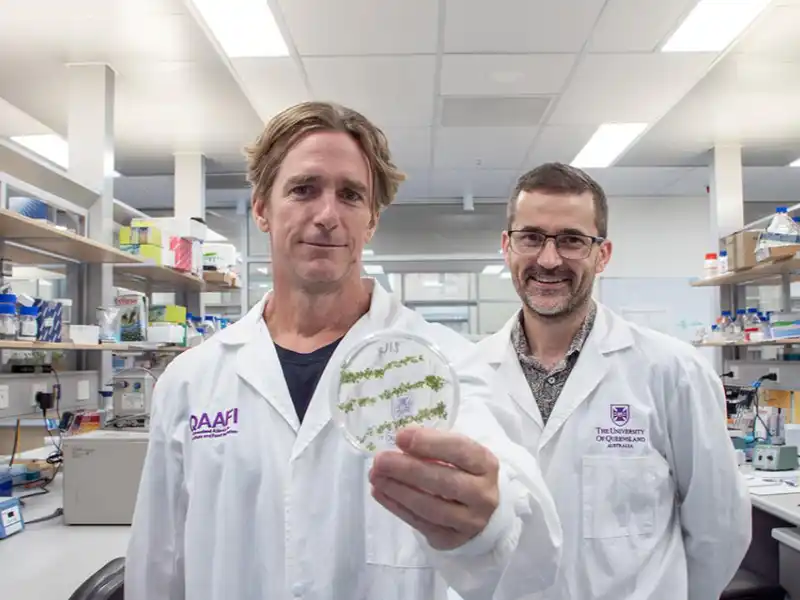
Moving biopesticides through plants opens new opportunities

Articles from the Web
-

How a young digital marketer built a second life as a hobby beekeeper in Croatia | Wikifarmer
-

Good fungus may one day help save plants from bad fungus like deadly myrtle rust disease
-

The Tree Church, Ohaupo, New Zealand
-

Managing Heat Stress in Nursery Environments
-

‘Nitrogen fixing’ trees could help tropical forests bounce back, research suggests
-

‘Soil is more important than oil’: inside the perennial grain revolution
-

The New York Earth Room
-

Researchers warn climate-linked disease leptospirosis spreading south
-
Moving biopesticides through plants opens new opportunities
-

The Veitch Nursery: A Family Dynasty c.1808-1969
-

How the garden sprinkler conquered Australia
-

Nematode diversity, food web condition, and chemical and physical properties in different soil habitats of an organic farm
